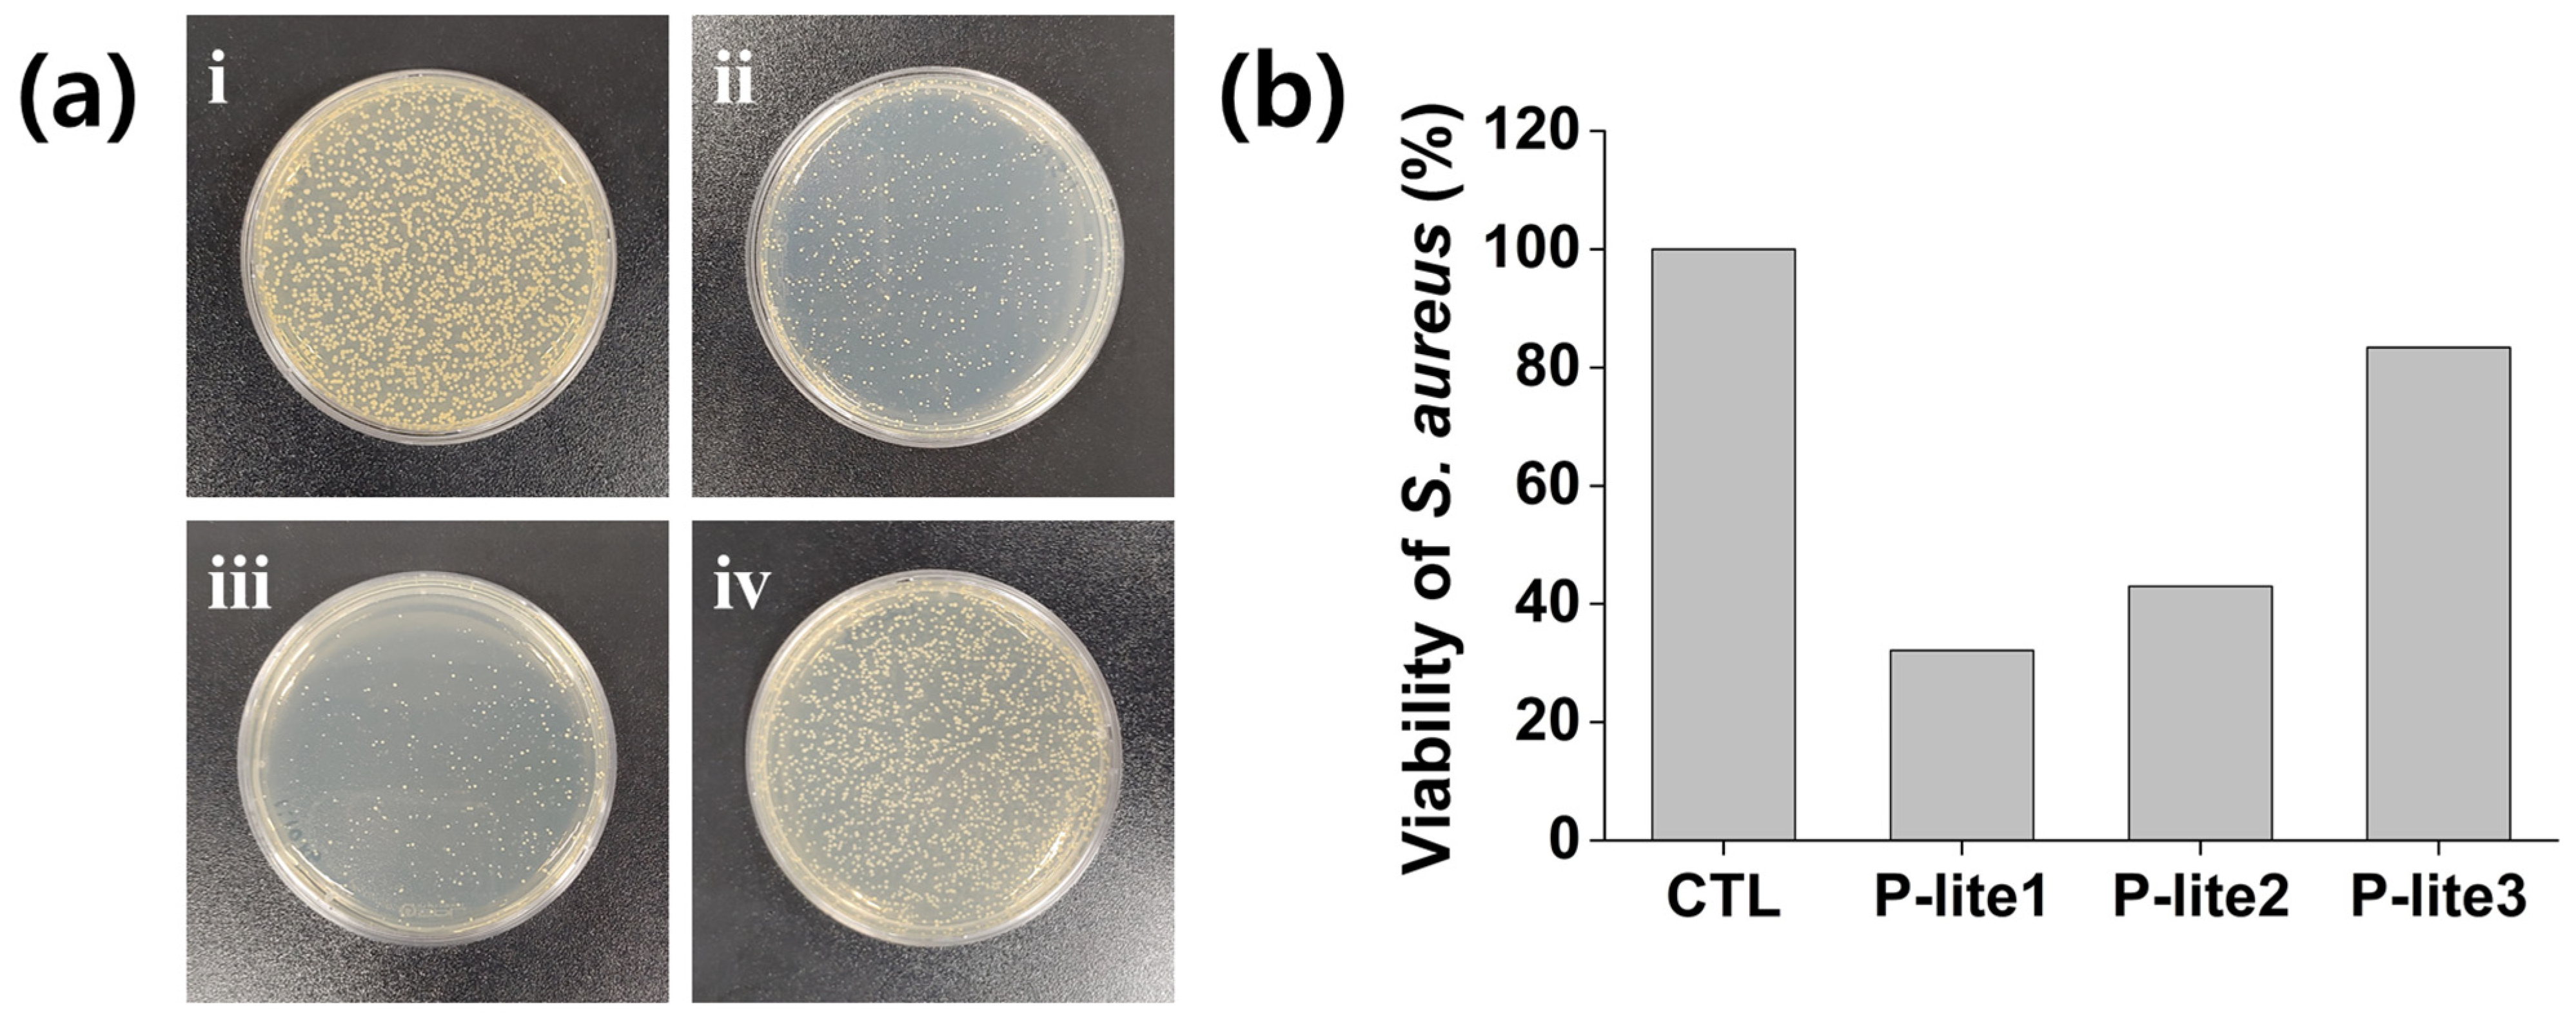
Polymers 13 04275 g007 Polymers 13 04275 g007

A Novel Polyvinylpyrrolidone-Stabilized Illite Microparticle with Enhanced Antioxidant and Antibacterial Effect
Abstract
1. Introduction
2. Materials and Methods
2.1. Materials
2.2. Preparation of P-Lite MPs
2.3. Characterization of P-Lite MPs
2.4. Stability of P-Lite MPs
2.5. In Situ Antioxidant Activity of P-Lite MPs
2.6. Antibacterial Activity of P-Lite MPs
2.7. In Vitro Cytotoxicity and Antioxidant Activity of P-Lite MPs
2.8. Statistical Analysis
3. Results and Discussion
3.1. Preparation and Characterization of P-Lite MPs
3.2. Stability of P-Lite MPs
3.3. Antioxidant Activity of P-Lite MPs
3.4. Antibacterial Activity of P-Lite MPs
3.5. In Vitro Cytotoxicity and Antioxidant Activity of P-Lite MPs
4. Conclusions
Author Contributions
Funding
Institutional Review Board Statement
Informed Consent Statement
Data Availability Statement
Conflicts of Interest
References
- Barton, C.D.; Karathanasis, A.D. Clay Minerals. In Encyclopedia of Soil Science; Lal, R., Ed.; Marcel Dekker: New York, NY, USA, 2002; p. 187. [Google Scholar]
- Ruiz-Hitzky, E.; Aranda, P.; Darder, M.; Rytwo, G. Hybrid materials based on clays for environmental and biomedical applications. J. Mater. Chem. 2010, 20, 9306–9321. [Google Scholar] [CrossRef]
- Kayode, A.D.; Sunday, A.S.; Oluyemi, A.S.; Adegalu, A.A.; Samson, O.O.; Abidemi, I.O.; Hellen, O.A. Clay soil modification techniques for the adsorption of heavy metals in aqueous medium: A review. Int. J. Adv. Res. Chem. Sci. 2019, 6, 14–31. [Google Scholar]
- Carretero, M.I. Clay minerals and their beneficial effects upon human health. A review. Appl. Clay Sci. 2002, 21, 155–163. [Google Scholar] [CrossRef]
- Zhang, G.; Kim, J.; Dong, H.; Sommer, A.J. Microbial effects in promoting the smectite to illite reaction: Role of organic matter intercalated in the interlayer. Am. Mineral. 2007, 92, 1401–1410. [Google Scholar] [CrossRef]
- Williams, L.B.; Haydel, S.E. Evaluation of the medicinal use of clay minerals as antibacterial agents. Int. Geol. Rev. 2010, 52, 745–770. [Google Scholar] [CrossRef] [PubMed]
- Williams, L.B.; Haydel, S.E.; Giese, R.F., Jr.; Eberl, D.D. Chemical and mineralogical characteristics of French green clays used for healing. Clays Clay Miner. 2008, 56, 437–452. [Google Scholar] [CrossRef]
- Morrison, K.D.; Underwood, J.C.; Metge, D.W.; Eberl, D.D.; Williams, L.B. Mineralogical variables that control the antibacterial effectiveness of a natural clay deposit. Environ. Geochem. Health 2014, 36, 613–631. [Google Scholar] [CrossRef]
- Uddin, M.K. A review on the adsorption of heavy metals by clay minerals, with special focus on the past decade. Chem. Eng. J. 2017, 308, 438–462. [Google Scholar] [CrossRef]
- Sabbagh, F.; Khatir, N.M.; Karim, A.K.; Omidvar, A.; Nazari, Z.; Jaberi, R. Mechanical properties and swelling behavior of acrylamide hydrogels using montmorillonite and kaolinite as clays. J. Environ. Treat. Tech. 2019, 7, 211–219. [Google Scholar]
- Sabbagh, F. A comparative study on the clays incorporated with acrylamide-based hydrogels. Adv. Appl. NanoBio-Technol. 2021, 2, 15–23. [Google Scholar]
- Murray, H.H. Bentonite applications. In Applied Clay Mineralogy: Occurrences, Processing and Applications of Kaolins, Bentonites, Palygorskitesepiolite, and Common Clays; Elsevier Science: Amsterdam, The Netherlands, 2006; p. 111. [Google Scholar]
- Varma, A.K. Shale mineralogy. In Shale Gas: Exploration and Environmental and Economic Impacts; Elsevier Science: Amsterdam, The Netherlands, 2017; p. 65. [Google Scholar]
- Luckham, P.F.; Rossi, S. The colloidal and rheological properties of bentonite suspensions. Adv. Colloid Interface Sci. 1999, 82, 43–92. [Google Scholar] [CrossRef]
- Deng, Y.; Dixon, J.B.; White, G.N. Adsorption of polyacrylamide on smectite, illite, and kaolinite. Soil Sci. Soc. Am. J. 2006, 70, 297–304. [Google Scholar] [CrossRef]
- Elbokl, T.A.; Detellier, C. Aluminosilicate nanohybrid materials. Intercalation of polystyrene in kaolinite. J. Phys. Chem. Solids 2006, 67, 950–955. [Google Scholar] [CrossRef]
- Murugesan, S.; Scheibel, T. Copolymer/clay nanocomposites for biomedical applications. Adv. Funct. Mater. 2020, 30, 1908101. [Google Scholar] [CrossRef]
- Viseras, C.; Cerezo, P.; Sanchez, R.; Salcedo, I.; Aguzzi, C. Current challenges in clay minerals for drug delivery. Appl. Clay Sci. 2010, 48, 291–295. [Google Scholar] [CrossRef]
- Sengwa, R.J.; Choudhary, S. Structural characterization of hydrophilic polymer blends/montmorillonite clay nanocomposites. J. Appl. Polym. Sci. 2014, 131, 40617. [Google Scholar] [CrossRef]
- Perez Huertas, S.; Terpiłowski, K.; Wiśniewska, M.; Zarko, V. Influence of polyvinylpyrrolidone adsorption on stability of silica aqueous suspension—Effects of polymer concentration and solid content. Physicochem. Probl. Miner. Process. 2017, 53, 121–135. [Google Scholar]
- Blum, A.E.; Eberl, D.D. Measurement of clay surface areas by polyvinylpyrrolidone (PVP) sorption and its use for quantifying illite and smectite abundance. Clays Clay Miner. 2004, 52, 589–602. [Google Scholar] [CrossRef]
- Rasmussen, M.K.; Pedersen, J.N.; Marie, R. Size and surface charge characterization of nanoparticles with a salt gradient. Nat. Commun. 2020, 11, 2337. [Google Scholar] [CrossRef]
- Chen, H.; Li, Q.; Wang, M.; Ji, D.; Tan, W. XPS and two-dimensional FTIR correlation analysis on the binding characteristics of humic acid onto kaolinite surface. Sci. Total Environ. 2020, 724, 138154. [Google Scholar] [CrossRef]
- Halliwell, B.; Gutteridge, J.M.; Aruoma, O.I. The deoxyribose method: A simple “test-tube” assay for determination of rate constants for reactions of hydroxyl radicals. Anal. Biochem. 1987, 165, 215–219. [Google Scholar] [CrossRef]
- Li, Q.; Sun, X.; Gu, G.; Guo, Z. Novel water soluble chitosan derivatives with 1,2,3-triazolium and their free radical-scavenging activity. Mar. Drugs 2018, 16, 107. [Google Scholar] [CrossRef]
- Shabbir, M.; Khan, M.R.; Saeed, N. Assessment of phytochemicals, antioxidant, anti-lipid peroxidation and anti-hemolytic activity of extract and various fractions of Maytenus royleanus leaves. BMC Complement. Altern. Med. 2013, 13, 143. [Google Scholar] [CrossRef]
- Prabu, K.; Natarajan, E. In vitro antimicrobial and antioxidant activity of chitosan isolated from podophthalmus vigil. J. Appl. Pharm. Sci. 2012, 2, 75–82. [Google Scholar] [CrossRef]
- Li, X.; Fu, T.; Li, B.; Yan, P.; Wu, Y. Riboflavin-protected ultrasmall silver nanoclusters with enhanced antibacterial activity and the mechanisms. RSC Adv. 2019, 9, 13275–13282. [Google Scholar] [CrossRef]
- Stuart, M.C.; Fleer, G.J.; Bijsterbosch, B.H. The adsorption of poly(vinyl pyrrolidone) onto silica. I. Adsorbed amount. J. Colloid Interface Sci. 1982, 90, 310–320. [Google Scholar] [CrossRef]
- Zhao, X.; Li, J.; Liu, Y.; Zhang, Y.; Qu, J.; Qi, T. Preparation and mechanism of TiO2-coated illite composite pigments. Dye. Pigm. 2014, 108, 84–92. [Google Scholar] [CrossRef]
- Koczkur, K.M.; Mourdikoudis, S.; Polavarapu, L.; Skrabalak, S.E. Polyvinylpyrrolidone (PVP) in nanoparticle synthesis. Dalton Trans. 2015, 44, 17883–17905. [Google Scholar] [CrossRef]
- Selvam, S.; Sundrarajan, M. Functionalization of cotton fabric with PVP/ZnO nanoparticles for improved reactive dyeability and antibacterial activity. Carbohydr. Polym. 2012, 87, 1419–1424. [Google Scholar] [CrossRef]
- Hong, H.; Churchman, G.J.; Yin, K.; Li, R.; Li, Z. Randomly interstratified illite-vermiculite from weathering of illite in red earth sediments in Xuancheng, southeastern China. Geoderma 2014, 214, 42–49. [Google Scholar] [CrossRef]
- Liu, H.; Zhang, B.; Shi, H.; Tang, Y.; Jiao, K.; Fu, X. Hydrothermal synthesis of monodisperse Ag2Se nanoparticles in the presence of PVP and KI and their application as oligonucleotide labels. J. Mater. Chem. 2008, 18, 2573–2580. [Google Scholar] [CrossRef]
- Al-Harbi, L.M.; Kosa, S.A.; Baloch, M.K.; Bhatti, Q.A.; El-Mossalamy, E.S.E.B.H. Adsorption of polyvinylpyrrolidone over the silica surface: As affected by pretreatment of adsorbate and molar mass of polymer adsorbent. Int. J. Polym. Sci. 2016, 2016, 1–9. [Google Scholar] [CrossRef]
- Ihekweme, G.O.; Shondo, J.N.; Orisekeh, K.I.; Kalu-Uka, G.M.; Nwuzor, I.C.; Onwualu, A.P. Characterization of certain Nigerian clay minerals for water purification and other industrial applications. Heliyon 2020, 6, e03783. [Google Scholar] [CrossRef] [PubMed]
- Meškinis, Š.; Vasiliauskas, A.; Andrulevičius, M.; Peckus, D.; Tamulevičius, S.; Viskontas, K. Diamond like carbon films containing Si: Structure and nonlinear optical properties. Materials 2020, 13, 1003. [Google Scholar] [CrossRef]
- Ball, R.L.; Bajaj, P.; Whitehead, K.A. Achieving long-term stability of lipid nanoparticles: Examining the effect of pH, temperature, and lyophilization. Int. J. Nanomed. 2017, 12, 305–315. [Google Scholar] [CrossRef] [PubMed]
- Soltani, N.; Saion, E.; Erfani, M.; Rezaee, K.; Bahmanrokh, G.; Drummen, G.P.; Bahrami, A.; Hussein, M.Z. Influence of the polyvinyl pyrrolidone concentration on particle size and dispersion of ZnS nanoparticles synthesized by microwave irradiation. Int. J. Mol. Sci. 2012, 13, 12412–12427. [Google Scholar] [CrossRef]
- Fitriani, L.; Rismawati, E.; Umar, S.; Zaini, E. Solid dispersion of usnic acid-PVP K30 and evaluation of antioxidant activity. Rasayan J. Chem. 2018, 11, 1643–1648. [Google Scholar] [CrossRef]
- Jeong, O.J.; Woo, K.S.; Kim, K.Y.; Lee, H.B.; Jeong, H.S. Effect of clay minerals treatment on the physicochemical characteristics and growth inhibition of microorganism of some foods. Korean J. Food Sci. Technol. 2005, 37, 23–29. [Google Scholar]
- Otto, C.C.; Kilbourne, J.; Haydel, S.E. Natural and ion-exchanged illite clays reduce bacterial burden and inflammation in cutaneous methicillin-resistant Staphylococcus aureus infections in mice. J. Med. Microbiol. 2016, 65, 19–27. [Google Scholar] [CrossRef]
- Bhatia, D.; Mittal, A.; Malik, D.K. Antimicrobial activity of PVP coated silver nanoparticles synthesized by Lysinibacillus varians. 3 Biotech 2016, 6, 196. [Google Scholar] [CrossRef] [PubMed]
- Williams, L.B.; Metge, D.W.; Eberl, D.D.; Harvey, R.W.; Turner, A.G.; Prapaipong, P.; Poret-Peterson, A.T. What makes a natural clay antibacterial? Environ. Sci. Technol. 2011, 45, 3768–3773. [Google Scholar] [CrossRef] [PubMed]
- Seong, D.M.; Lee, H.; Kim, J.; Chang, J.H. High oxygen and water-vapor transmission rate and in vitro cytotoxicity assessment with illite-polyethylene packaging films. Materials 2020, 13, 2382. [Google Scholar] [CrossRef] [PubMed]
- Kurakula, M.; Rao, G.S.N.K. Pharmaceutical assessment of polyvinylpyrrolidone (PVP): As excipient from conventional to controlled delivery systems with a spotlight on COVID-19 inhibition. J. Drug Deliv. Sci. Technol. 2020, 60, 102046. [Google Scholar] [CrossRef] [PubMed]
- Maisanaba, S.; Pichardo, S.; Puerto, M.; Praena, D.G.; Cameán, A.M.; Jos, A. Toxicological evaluation of clay minerals and derived nanocomposites: A review. Environ. Res. 2015, 138, 233–254. [Google Scholar] [CrossRef] [PubMed]

Publisher’s Note: MDPI stays neutral with regard to jurisdictional claims in published maps and institutional affiliations. |
© 2021 by the authors. Licensee MDPI, Basel, Switzerland. This article is an open access article distributed under the terms and conditions of the Creative Commons Attribution (CC BY) license (https://creativecommons.org/licenses/by/4.0/).
Share and Cite
Oh, H.; Lee, J.S.; Lee, H.S.; Sung, D.; Choi, W.I. A Novel Polyvinylpyrrolidone-Stabilized Illite Microparticle with Enhanced Antioxidant and Antibacterial Effect. Polymers 2021, 13, 4275. https://doi.org/10.3390/polym13244275
Oh H, Lee JS, Lee HS, Sung D, Choi WI. A Novel Polyvinylpyrrolidone-Stabilized Illite Microparticle with Enhanced Antioxidant and Antibacterial Effect. Polymers. 2021; 13(24):4275. https://doi.org/10.3390/polym13244275
Chicago/Turabian StyleOh, Hyeryeon, Jin Sil Lee, Hye Sun Lee, Daekyung Sung, and Won Il Choi. 2021. "A Novel Polyvinylpyrrolidone-Stabilized Illite Microparticle with Enhanced Antioxidant and Antibacterial Effect" Polymers 13, no. 24: 4275. https://doi.org/10.3390/polym13244275
APA StyleOh, H., Lee, J. S., Lee, H. S., Sung, D., & Choi, W. I. (2021). A Novel Polyvinylpyrrolidone-Stabilized Illite Microparticle with Enhanced Antioxidant and Antibacterial Effect. Polymers, 13(24), 4275. https://doi.org/10.3390/polym13244275

